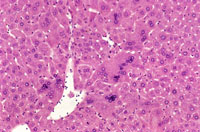
Multinucleated Hepatocytes

The Digitized Atlas of Mouse Liver Lesions

Much of the work carried out by DTT is in support of the National Toxicology Program (NTP), an interagency partnership of the Food and Drug Administration, National Institute for Occupational Safety and Health, and NIEHS.
Visit the NTP WebsiteAdult mouse liver with scattered multinucleated hepatocytes
A mouse treated chronically with chlordane, showing enlarged hepatocytes with multiple nuclei.
Multinucleated hepatocytes in a B6C3F1 male mouse.